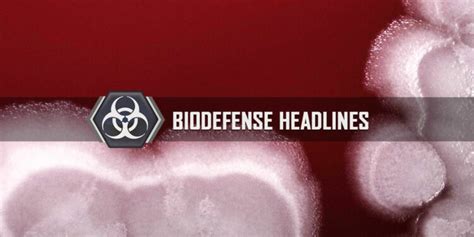

Global Headlines: January 21, 2023
Global Headlines: January 21, 2023
Hey everyone, and welcome back to your daily dose of what’s happening around the globe! Today is January 21st, 2023, and as always, the world stage is buzzing with activity. We’ve got a mix of crucial political developments, economic shifts, and some ongoing stories that continue to shape our world. Let’s dive right in and break down the most significant international news stories you need to know about today.
Table of Contents
Key Developments in Eastern Europe
The ongoing situation in Eastern Europe continues to be a dominant focus in international news . Tensions remain high, with diplomatic efforts constantly underway to de-escalate the conflict and find a peaceful resolution. Analysts are closely watching any troop movements, statements from world leaders, and the impact of sanctions on the global economy. The humanitarian aspect is also a critical concern, with aid organizations working tirelessly to support those affected by the crisis. We’ll be keeping a close eye on any developments from the front lines, as well as any breakthroughs or setbacks in peace talks. The international community’s unified response, or lack thereof, will be a key indicator of future geopolitical stability. The resilience of the people on the ground , enduring immense hardship, is a stark reminder of the human cost of these conflicts. Furthermore, the ripple effects of this conflict are felt far beyond the immediate region, impacting energy markets, food security, and global supply chains. Discussions around potential long-term security arrangements in Europe are also gaining traction, reflecting a significant shift in the continent’s security architecture. The sheer scale of the displacement of people is a humanitarian crisis that demands sustained international attention and support. We are seeing an unprecedented level of coordinated sanctions aimed at pressuring key actors, but their effectiveness and unintended consequences are subjects of ongoing debate. The role of international organizations in mediating and providing humanitarian aid is more crucial than ever, highlighting the complex web of diplomacy and action required to navigate such a volatile geopolitical landscape. The determination of nations to uphold international law and sovereignty is being tested, and the outcomes of these challenges will undoubtedly shape international relations for years to come.
Economic Forecasts and Global Markets
Shifting gears to the world of global economics , today’s headlines are filled with updates on inflation, interest rates, and the overall health of the global economy. Central banks around the world are making critical decisions that will impact everything from your wallet to major international trade. Inflation remains a persistent worry for many economies, prompting aggressive monetary policies. We’ll be looking at reports from major financial institutions for their latest economic forecasts, paying close attention to projections for growth, unemployment, and consumer spending. The energy sector, in particular, is experiencing significant volatility, influencing broader economic trends. Understanding these economic indicators is crucial for businesses and individuals alike as we navigate these uncertain times. The interplay between monetary policy and fiscal stimulus measures is a delicate balancing act, with policymakers aiming to curb inflation without triggering a recession. The performance of emerging markets is also a key area of interest, as they often serve as bellwethers for global economic health. Investment trends, currency fluctuations, and the flow of capital across borders are all critical components of the economic puzzle. We are seeing a continued push towards digital transformation in finance, with advancements in fintech and blockchain technology potentially reshaping how we conduct transactions and manage investments. The sustainability of economic growth is a major talking point, with increasing attention paid to environmental, social, and governance (ESG) factors. Companies and investors are recognizing the long-term value of responsible business practices. The latest trade data will also provide insights into the health of international commerce, revealing shifts in demand and supply dynamics. Navigating the complexities of global trade agreements and tariffs remains a significant challenge for many nations seeking to foster economic cooperation and growth. The overall sentiment in the markets, whether optimistic or cautious, will be a crucial factor influencing investment decisions and business confidence worldwide. The quest for stable and predictable economic policies is a constant endeavor for governments aiming to attract foreign investment and promote domestic prosperity. The effectiveness of supply chain resilience initiatives will also be closely scrutinized as businesses seek to mitigate risks associated with global disruptions.
Climate Action and Environmental Initiatives
On the environmental front, advancements in climate action are making waves in international news. Discussions around renewable energy targets, carbon emissions reduction, and sustainable development are gaining momentum. We’re seeing a stronger commitment from governments and corporations to adopt greener practices and invest in clean technologies. Reports on the latest scientific findings regarding climate change are also likely to be prominent, underscoring the urgency of the situation. The role of international cooperation in tackling this global challenge cannot be overstated. From policy initiatives to technological innovations, the world is striving to find effective solutions. The push for a circular economy, where resources are reused and recycled, is gaining traction as a viable model for sustainable consumption. The impact of extreme weather events globally serves as a constant reminder of the pressing need for action. Efforts to protect biodiversity and conserve natural habitats are also integral to the broader environmental agenda. We are seeing an increasing number of companies setting ambitious net-zero targets and investing in renewable energy sources like solar and wind power. The development of innovative carbon capture technologies offers a glimmer of hope in mitigating the effects of industrial emissions. International summits and conferences dedicated to climate change continue to be crucial platforms for setting global agendas and forging partnerships. The transition to electric vehicles and the expansion of charging infrastructure are significant steps towards decarbonizing the transportation sector. Public awareness and engagement on environmental issues are at an all-time high, driving demand for more sustainable products and services. The concept of climate justice, addressing the disproportionate impact of climate change on vulnerable communities, is also a central theme in many discussions. The commitment to preserving our planet for future generations requires a multifaceted approach involving policy, technology, and individual action. The progress made in reforestation and afforestation projects worldwide is a positive sign, contributing to carbon sequestration and ecosystem restoration. The challenges are immense, but the collective will to address climate change appears to be growing stronger, fueled by scientific evidence and a shared sense of responsibility.
Social and Cultural Highlights
Beyond politics and economics, significant social and cultural events are capturing attention. From major sporting competitions to artistic exhibitions and humanitarian efforts, these stories highlight the diversity and richness of human experience. We’ll be keeping an eye on any major breakthroughs in science and technology that could impact our daily lives. Cultural exchanges and collaborations between nations foster understanding and appreciation for different traditions. Charitable initiatives and movements aimed at addressing social inequalities also feature prominently. The latest trends in global health and wellness, including advancements in medical research and public health campaigns, are important to follow. The power of storytelling through film, literature, and other media continues to connect people across borders and perspectives. We are seeing a surge in interest in indigenous cultures and traditions, with efforts to preserve and promote them gaining momentum. The organization of international festivals and events celebrating art, music, and cuisine plays a vital role in fostering cross-cultural dialogue. The ongoing efforts to promote education and literacy worldwide are fundamental to empowering individuals and communities. The debate around artificial intelligence and its ethical implications is a major topic of discussion in both scientific and social circles. The enduring spirit of human connection and collaboration shines through in countless stories of resilience, innovation, and compassion. The accessibility of information through the internet has democratized knowledge and facilitated the sharing of ideas on a global scale. The exploration of space and the pursuit of scientific discovery continue to inspire awe and wonder, pushing the boundaries of human understanding. The evolution of social media platforms and their impact on communication and social interaction is a dynamic area of study. The importance of preserving cultural heritage sites and artifacts for future generations is a shared global responsibility.
Looking Ahead
As we wrap up today’s international news roundup for January 21st, 2023, it’s clear that our world is a complex and interconnected place. The stories we’ve covered today—from geopolitical tensions to economic shifts and environmental concerns—all highlight the challenges and opportunities that lie ahead. Staying informed is more important than ever , and we’ll continue to bring you the most critical updates. Keep an eye out for our next report as we navigate the ever-changing global landscape together. Thanks for tuning in, guys!